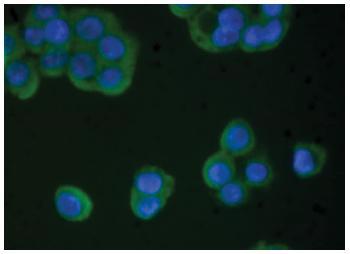

Mouse Anti-Human TIMP-4 (Discontinued)
Figure 1: Human pancreatic carcinoma cells were stained with Mouse Anti-Human TIMP-4 followed by Goat Anti-Mouse Ig, Human ads-FITC .
Roll over image to zoom in

Shipping Info:
For estimated delivery dates, please contact us at [email protected]
Amount : | 0.1 mg |
Isotype : | Mouse IgG2a, kappa |
Content : | 0.5 mg/ml, 0.2 ml, Supplied in borate buffered saline, pH 8.2; No preservatives or amine-containing buffer salts added |
Storage condition : | Store at 2-8°C |
Subcellular location: | Secreted |
Tissue Specificity: | Abundant in heart and present at low levels in many other tissues. |
BioGrid: | 112935. 4 interactions. |
There are currently no product reviews
|